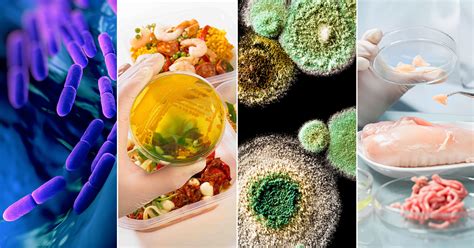

Microbial-Based Foods: A Delicious Revolution
Microbial-Based Foods: A Delicious Revolution
Hey guys! Ever stopped to think about the tiny armies working tirelessly to bring some of your favorite foods to life? We’re talking about microbes ! These little guys are the unsung heroes behind a huge range of delicious and nutritious food products. Let’s dive into the fascinating world of microbial-based foods and uncover how they’re revolutionizing our plates.
Table of Contents
What are Microbial-Based Foods?
So, what exactly are microbial-based foods? Simply put, these are food products that rely on the action of microorganisms like bacteria, fungi, and yeast during their production. Think of it as harnessing the power of nature’s smallest chefs to create culinary masterpieces! The use of microbes in food production isn’t new; in fact, it’s an ancient practice. For centuries, humans have been using microorganisms to ferment, preserve, and enhance the flavor and nutritional value of foods. From the tangy zest of yogurt to the complex flavors of aged cheese, microbes are essential. But beyond these traditional applications, modern biotechnology is pushing the boundaries of what’s possible, leading to innovative and sustainable food solutions using microbial power. These foods aren’t just about funky flavors; they’re about sustainability, nutrition, and food security. By understanding and harnessing the capabilities of microbes , we can unlock new sources of protein, develop healthier alternatives, and reduce our environmental footprint. Isn’t that neat? In a world grappling with increasing food demands and environmental concerns, microbial-based foods offer a promising path forward, blending tradition with cutting-edge science. The role of microbes is not limited to just fermentation; they are also vital in producing food additives, enzymes, and even novel proteins. This wide range of applications highlights the versatility and importance of microbial technology in shaping the future of food. As research continues to uncover the vast potential of the microbial world, we can expect even more exciting developments in microbial-based foods, transforming the way we eat and nourishing our planet.
Traditional Microbial-Based Foods
Let’s take a trip down memory lane and explore some of the traditional microbial-based foods that have been staples in cultures around the world for ages! These aren’t your fancy lab-grown alternatives; these are the tried-and-true classics that have delighted taste buds for generations. Think of yogurt , for example. This creamy delight is made by fermenting milk with specific bacteria cultures, like Lactobacillus and Streptococcus . These bacteria munch on the lactose (milk sugar), producing lactic acid, which gives yogurt its signature tangy flavor and thick texture. Then there’s cheese , another fermented dairy product with a mind-boggling variety of flavors and textures. Different types of bacteria and molds are used to create everything from the mildest mozzarella to the sharpest cheddar. These microbes not only contribute to the flavor but also break down proteins and fats, influencing the texture and digestibility of the cheese. Don’t forget about sauerkraut , a fermented cabbage dish that’s popular in many European countries. Bacteria ferment the cabbage, producing lactic acid and other compounds that give it a sour and tangy flavor, not to mention a healthy dose of probiotics! And of course, we can’t forget kimchi , Korea’s beloved fermented vegetable dish. Similar to sauerkraut, kimchi relies on bacteria to ferment a mix of vegetables, creating a spicy, sour, and incredibly flavorful condiment that’s packed with probiotics and nutrients. These traditional microbial-based foods aren’t just delicious; they’re also incredibly nutritious. The fermentation process can enhance the bioavailability of nutrients, making them easier for our bodies to absorb. Plus, many fermented foods are rich in probiotics, which are beneficial bacteria that can support gut health and boost our immune system. So, the next time you enjoy a bowl of yogurt, a slice of cheese, or a spoonful of sauerkraut, take a moment to appreciate the microbial magic that makes these foods so special. They are not just food; they are a testament to the power of microbes in transforming raw ingredients into culinary treasures.
Modern Microbial-Based Foods
Okay, now let’s fast forward to the present and check out some of the modern and innovative microbial-based foods that are shaking up the food industry! These aren’t your grandma’s fermented goodies; we’re talking about cutting-edge technologies and sustainable solutions. One of the most exciting developments is single-cell protein (SCP) . This involves growing microorganisms like bacteria , yeast , and algae in large-scale bioreactors and then harvesting their protein-rich biomass. SCP can be used as a protein source in animal feed or processed into human food products. It’s a highly efficient and sustainable way to produce protein, as microbes can grow rapidly and require minimal land and resources. Another area of innovation is in alternative meats . Companies are using microbial fermentation to create meat substitutes that mimic the taste and texture of real meat. For example, some companies are using fungi to grow mycelium, the root-like structure of mushrooms , which can then be processed into meat-like products. Others are using bacteria to produce heme, the iron-containing molecule that gives meat its characteristic flavor and color. These microbial-based meat alternatives offer a more sustainable and ethical way to enjoy the flavors and textures of meat without the environmental and ethical concerns associated with traditional animal agriculture. Beyond protein, microbes are also being used to produce a variety of other food ingredients, such as vitamins , enzymes , and flavorings . For example, bacteria can be engineered to produce specific vitamins , which can then be added to food products to enhance their nutritional value. Enzymes produced by microbes are widely used in the food industry to improve the texture, flavor, and shelf life of various foods. And microbial fermentation can be used to create unique and complex flavorings that enhance the taste of everything from sauces to snacks. These modern applications of microbial technology are revolutionizing the food industry, offering sustainable, nutritious, and delicious alternatives to traditional food production methods. As research continues to advance, we can expect even more exciting innovations in microbial-based foods , shaping the future of our plates and our planet.
Benefits of Microbial-Based Foods
Alright, let’s talk about the amazing benefits of incorporating microbial-based foods into your diet! It’s not just about the cool science; it’s about how these foods can boost your health and help the planet. First off, many microbial-based foods are packed with nutrients . Fermented foods, like yogurt, kimchi, and sauerkraut, are rich in probiotics , those friendly bacteria that support a healthy gut. A healthy gut is linked to improved digestion, a stronger immune system, and even better mental health. Plus, the fermentation process can increase the bioavailability of certain nutrients , making them easier for your body to absorb. Microbial-based foods can also be a great source of protein . Single-cell protein, for example, is a highly efficient and sustainable way to produce protein, and it can be a valuable source of essential amino acids. And with the rise of microbial-based meat alternatives, you can enjoy the flavors and textures of meat without the environmental and ethical concerns associated with traditional animal agriculture. But the benefits of microbial-based foods extend beyond nutrition. These foods can also be incredibly sustainable . Microbes can be grown using minimal land, water, and energy, making them a much more environmentally friendly alternative to traditional agriculture. Plus, microbial fermentation can be used to upcycle food waste, turning it into valuable food ingredients. By reducing our reliance on traditional agriculture and embracing microbial-based food production, we can significantly reduce our environmental footprint and create a more sustainable food system. In addition to their nutritional and environmental benefits , microbial-based foods can also be incredibly versatile and delicious . From the tangy zest of yogurt to the umami-rich flavors of miso, microbial-based foods offer a wide range of tastes and textures to explore. And with the growing popularity of microbial-based meat alternatives, you can enjoy your favorite meaty dishes without compromising your values or your health. So, whether you’re a health-conscious foodie, an environmental activist, or simply someone who loves to try new things, microbial-based foods have something to offer. By incorporating these foods into your diet, you can nourish your body, protect the planet, and discover a whole new world of culinary delights.
Potential Challenges and Considerations
Now, let’s be real – no revolution comes without its bumps in the road. While microbial-based foods hold immense promise, there are some potential challenges and considerations we need to address. One of the biggest challenges is consumer acceptance . Let’s face it, the idea of eating food made with microbes can be a bit off-putting for some people. Overcoming this challenge requires clear and transparent communication about the safety, nutritional value, and environmental benefits of microbial-based foods . Education is key to dispelling misconceptions and building trust. Another consideration is regulation . As microbial-based foods become more prevalent, governments need to establish clear and consistent regulations to ensure their safety and quality. This includes setting standards for the production, labeling, and marketing of these foods. Regulations should be based on sound scientific evidence and should be designed to protect consumers without stifling innovation. Scalability is another challenge . While microbial-based food production is highly efficient, scaling up production to meet the demands of a growing global population requires significant investment in infrastructure and technology. This includes building large-scale bioreactors, optimizing fermentation processes, and developing efficient harvesting and processing methods. Furthermore, it’s crucial to consider the environmental impact of microbial-based food production. While these methods are generally more sustainable than traditional agriculture, they still require energy and resources. Minimizing the environmental footprint of microbial-based food production requires using renewable energy sources, reducing water consumption, and implementing waste management strategies. Finally, we need to consider the ethical implications of microbial-based food production. This includes ensuring that these technologies are used responsibly and that the benefits are shared equitably. We need to avoid creating new forms of inequality or exacerbating existing ones. By addressing these challenges and considerations proactively, we can ensure that microbial-based foods reach their full potential and contribute to a more sustainable, equitable, and delicious future for all.
The Future of Food?
So, what does the future hold for microbial-based foods ? Honestly, the possibilities are endless! As technology advances and our understanding of the microbial world deepens, we can expect to see even more innovative and exciting applications of microbial technology in the food industry. Imagine a future where personalized nutrition is the norm, where you can get food tailored to your specific microbiome and dietary needs. Microbial fermentation could be used to produce customized probiotics, vitamins , and other nutrients that optimize your health. Or picture a future where food waste is a thing of the past, where microbial fermentation is used to upcycle agricultural byproducts and food scraps into valuable food ingredients. This could help reduce food waste, create new economic opportunities, and build a more circular food system. And what about the possibility of creating entirely new food experiences? Microbial fermentation could be used to create novel flavors, textures, and aromas that have never been experienced before. This could lead to a whole new world of culinary creativity and innovation. But perhaps the most exciting prospect is the potential of microbial-based foods to help solve some of the world’s most pressing challenges. By providing sustainable and nutritious alternatives to traditional agriculture, microbial-based foods can help address food security, reduce environmental degradation, and improve public health. The future of food is not just about what we eat; it’s about how we produce it. By embracing microbial technology and harnessing the power of the microbial world, we can create a food system that is more sustainable, resilient, and equitable. So, get ready to embrace the microbial revolution! The future of food is here, and it’s delicious, nutritious, and sustainable.